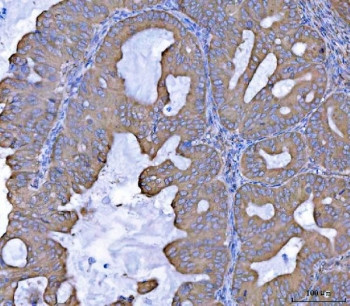
Anti-SEPT7 / Septin 7

Cookie preferences
This website uses cookies, which are necessary for the technical operation of the website and are always set. Other cookies, which increase the comfort when using this website, are used for direct advertising or to facilitate interaction with other websites and social networks, are only set with your consent.
Configuration
Technically required
These cookies are necessary for the basic functions of the shop.
"Allow all cookies" cookie
"Decline all cookies" cookie
CSRF token
Cookie preferences
Currency change
Customer-specific caching
FACT-Finder tracking
Individual prices
Selected shop
Session
Comfort functions
These cookies are used to make the shopping experience even more appealing, for example for the recognition of the visitor.
Note
Show the facebook fanpage in the right blod sidebar
Statistics & Tracking
Affiliate program
Conversion and usertracking via Google Tag Manager
Track device being used
| Item number | Size | Datasheet | Manual | SDS | Delivery time | Quantity | Price |
|---|---|---|---|---|---|---|---|
| NSJ-RQ7250 | 100 µg | - | - |
3 - 10 business days* |
790.00€
|
If you have any questions, please use our Contact Form.
You can also order by e-mail: info@biomol.com
Larger quantity required? Request bulk
You can also order by e-mail: info@biomol.com
Larger quantity required? Request bulk
0.5mg/ml if reconstituted with 0.2ml sterile DI water. This gene encodes a protein that is highly... more
Product information "Anti-SEPT7 / Septin 7"
0.5mg/ml if reconstituted with 0.2ml sterile DI water. This gene encodes a protein that is highly similar to the CDC10 protein of Saccharomyces cerevisiae. The protein also shares similarity with Diff 6 of Drosophila and with H5 of mouse. Each of these similar proteins, including the yeast CDC10, contains a GTP-binding motif. The yeast CDC10 protein is a structural component of the 10 nm filament which lies inside the cytoplasmic membrane and is essential for cytokinesis. This human protein functions in gliomagenesis and in the suppression of glioma cell growth, and it is required for the association of centromere-associated protein E with the kinetochore. Alternative splicing results in multiple transcript variants. Several related pseudogenes have been identified on chromosomes 5, 7, 9, 10, 11, 14, 17 and 19. Protein function: Filament-forming cytoskeletal GTPase. Required for normal organization of the actin cytoskeleton. Required for normal progress through mitosis. Involved in cytokinesis. Required for normal association of CENPE with the kinetochore. Plays a role in ciliogenesis and collective cell movements. Forms a filamentous structure with SEPTIN12, SEPTIN6, SEPTIN2 and probably SEPTIN4 at the sperm annulus which is required for the structural integrity and motility of the sperm tail during postmeiotic differentiation (PubMed:25588830). [The UniProt Consortium]
| Keywords: | Anti-CDC10, Anti-Septin-7, Anti-CDC10 protein homolog, SEPT7 Antibody / Septin 7 |
| Supplier: | NSJ Bioreagents |
| Supplier-Nr: | RQ7250 |
Properties
| Application: | WB, IHC (paraffin), FC, IF, Direct ELISA |
| Antibody Type: | Polyclonal |
| Conjugate: | No |
| Host: | Rabbit |
| Species reactivity: | human, mouse, rat |
| Immunogen: | Recombinant human protein (amino acids M1-K351) |
| Format: | Adhesion & Structure |
Database Information
| KEGG ID : | K16944 | Matching products |
| UniProt ID : | Q16181 | Matching products |
| Gene ID : | GeneID 989 | Matching products |
Handling & Safety
| Storage: | +4°C |
| Shipping: | +4°C (International: +4°C) |
Caution
Our products are for laboratory research use only: Not for administration to humans!
Our products are for laboratory research use only: Not for administration to humans!
Information about the product reference will follow.
more
You will get a certificate here
Viewed